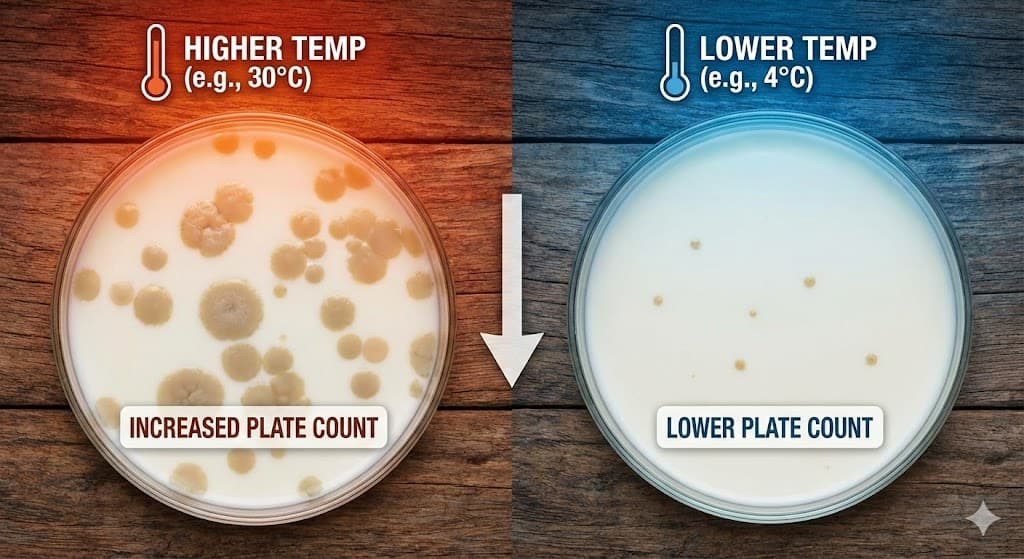
Coliform in Milk -Look Beyond Brands to Cold Chain Gaps

Recent independent lab tests have triggered alarm over coliform bacteria and high total plate counts (TPC) in popular pouch milk brands — Amul Taaza, Amul Gold, Mother Dairy and Country Delight — with counts far exceeding FSSAI’s safety limits in some samples. Amul Taaza’s coliform levels were reported at 98× the prescribed limit, Mother Dairy’s cow milk showed TPC nearly eight times higher than the FSSAI cap, and Country Delight also exceeded safe thresholds, raising concerns about hygiene and milk safety for everyday consumers.
Coliform bacteria — including strains like E. coli — are used as indicators of potential contamination, although higher counts don’t always mean direct fecal contamination. They often signal hygiene lapses at some point in the chain or re-contamination after heat treatment, necessitating cautious interpretation and public health measures.
While pasteurisation — heating milk to kill most pathogens — makes milk safer to drink and extends shelf life, it does not sterilise milk completely. If the cold chain (refrigerated transport and storage) is disrupted, residual bacteria that survive pasteurisation can multiply rapidly, especially in Indian conditions with high ambient temperatures. Many consumers still boil pasteurised milk at home as a precaution, reflecting doubts about refrigeration consistency from factory to retail shelf and into households.
We can generally say that almost every sample of pasteurized milk will see a rapid, significant growth in Standard Plate Count (SPC) and coliform bacteria if it is kept at higher temperatures (e.g., room temperature, 20°C–30°C+) rather than maintaining a strict cold chain (below 4°C–7°C).
Insight from Kuldeep Sharma:
“This controversy underscores what no one in the dairy sector talks about enough — poor cold chain management across India’s milk supply lines,” says dairy sector expert Kuldeep Sharma. “Pasteurised milk is inherently safe when the temperature is maintained below the recommended 4 °C from processing through transport to final retail. But in India, there is no regulatory mandate requiring milk to be sold strictly under refrigerated conditions outside of manufacturing facilities. Even short breaks in the cold chain — at distribution depots, local shops or during home storage — can allow bacteria to regrow despite initial pasteurisation. Solving this requires systemic upgrades to cold chain infrastructure, stricter enforcement of temperature controls and clear guidelines that pasteurised milk must be kept refrigerated at every stage until consumption.”
Industry bodies and consumer advocates are now calling for a full review of hygiene audits across the dairy supply chain, from milking practices and processing hygiene to transport, retail handling and cold storage enforcement. They argue that without strong protocols and real-time temperature monitoring, packaged milk can become vulnerable to bacterial growth even when initial quality checks at the factory are robust.
Milk safety concerns have reignited broader debates about food safety regulation in India, with critics questioning whether the current Food Safety and Standards Authority of India (FSSAI) framework and enforcement mechanisms adequately address hygiene and cold chain gaps amid India’s complex and diverse dairy supply networks.
Source : Dairynews7x7 Feb 12th 2026 by Kuldeep Sharma
#MilkSafety #ColiformAlert #PasteurisedMilk #ColdChainCrisis #DairyQuality #FSSAI #ConsumerHealth